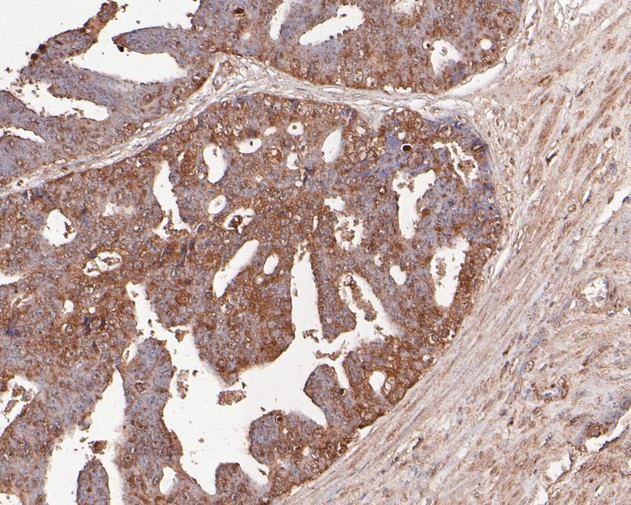
TNFRSF19 Antibody in Immunohistochemistry (Paraffin) (IHC (P))

Search
Invitrogen
TNFRSF19 Recombinant Rabbit Monoclonal Antibody (JE54-51)
{{$productOrderCtrl.translations['antibody.pdp.commerceCard.promotion.promotions']}}
{{$productOrderCtrl.translations['antibody.pdp.commerceCard.promotion.viewpromo']}}
{{$productOrderCtrl.translations['antibody.pdp.commerceCard.promotion.promocode']}}: {{promo.promoCode}} {{promo.promoTitle}} {{promo.promoDescription}}. {{$productOrderCtrl.translations['antibody.pdp.commerceCard.promotion.learnmore']}}
图: 1 / 4
TNFRSF19 Antibody (MA5-36190) in IHC (P)




Please note: We are reviewing Western blot images included in the antibody testing data in our catalog, including those provided by third parties. Unless expressly labeled or annotated as “raw-unedited”, Western blot images included in the antibody testing data in our catalog may have been edited, optimized or otherwise adjusted for presentation.
产品信息
MA5-36190
种属反应
宿主/亚型
Expression System
分类
类型
克隆号
抗原
偶联物
形式
浓度
规格
纯化类型
保存液
内含物
保存条件
运输条件
RRID
靶标信息
Tumor necrosis factor receptor superfamily member 19, commonly known as TROY, is a gene located on chromosome 1p36.22 that encodes a member of the tumor necrosis factor receptor (TNFR) superfamily. TROY is expressed in the nervous system, skin, and various tissues, where it plays a role in regulating cell apoptosis, inflammation, and development. As a receptor, TROY interacts with ligands and other signaling molecules to modulate pathways involved in cell survival, differentiation, and immune responses. In the context of the nervous system, TROY has been implicated in axonal outgrowth and regeneration, particularly influencing signaling pathways related to neural development and repair. Additionally, TROY has been studied in cancer research due to its potential role in tumor growth and progression, making it a candidate for therapeutic targeting. Its involvement in diverse biological processes highlights its significance in maintaining cellular homeostasis and its potential as a therapeutic target in neurobiology and oncology.
仅用于科研。不用于诊断过程。未经明确授权不得转售。
篇参考文献 (0)
生物信息学
蛋白别名: Toxicity and JNK inducer; TRADE; Tumor necrosis factor receptor superfamily member 19
基因别名: AL023044; AW123854; RGD1564996; TAJ; TAJ-ALPHA; TNFRSF19; TRADE; TROY; UNQ1888/PRO4333
UniProt ID: (Mouse) Q9JLL3
Entrez Gene ID: (Rat) 290300, (Mouse) 29820